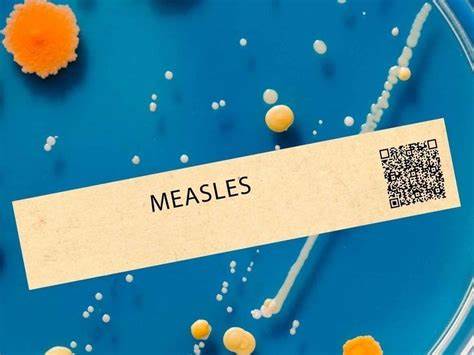

সান বার্নার্ডিনোতে জ্বালানি কার্ড জালিয়াতির অভিযোগে একজন গ্রেপ্তার
লস এঞ্জেলেস কাউন্টিতে হামের নতুন রোগী শনাক্ত
ছবিঃ এলএবাংলাটাইমস
লস এঞ্জেলেস কাউন্টি জনস্বাস্থ্য বিভাগ শুক্রবার জানিয়েছে, কাউন্টির এক বাসিন্দার শরীরে হামের সংক্রমণ নিশ্চিত করা হয়েছে। ওই ব্যক্তি সম্প্রতি টেক্সাস ভ্রমণ করে এসেছিলেন।
বিভাগের তথ্য অনুযায়ী, ভ্রমণের সময় ব্যক্তি সংক্রামক ছিলেন না। তবে স্বাস্থ্য কর্মকর্তারা এখন সম্ভাব্য সংক্রমিতদের শনাক্ত এবং তাদের টিকাদান অবস্থা যাচাই করার কাজ করছেন।
লস এঞ্জেলেস কাউন্টির স্বাস্থ্য কর্মকর্তা ড. মুন্টু ডেভিস বলেন, "হাম একটি গুরুতর শ্বাসযন্ত্রের রোগ, যা বাতাস এবং বিভিন্ন পৃষ্ঠের মাধ্যমে সহজেই ছড়িয়ে পড়ে, বিশেষ করে যারা টিকাপ্রাপ্ত নন তাদের মধ্যে। উপসর্গ প্রকাশের আগেও একজন ব্যক্তি অন্যদের সংক্রমিত করতে পারেন এবং সংক্রমণের ৭ থেকে ২১ দিনের মধ্যে লক্ষণ দেখা দিতে পারে।"
হামের প্রধান উপসর্গগুলো হলো:
উচ্চ জ্বর (১০৪ ডিগ্রি ফারেনহাইটের বেশি হতে পারে)
কাশি
সর্দি
লাল, পানিপূর্ণ চোখ
সাধারণত সংক্রমণের ৭ থেকে ১৪ দিনের মধ্যে এসব লক্ষণ প্রকাশ পায়।
জনস্বাস্থ্য বিভাগ বাসিন্দাদের প্রতি আহ্বান জানিয়েছে:
নিজেদের টিকাদান ও চিকিৎসা রেকর্ড পর্যালোচনা করুন, বিশেষ করে ভ্রমণের আগে।
গর্ভবতী নারী, শিশু, দুর্বল রোগ প্রতিরোধক্ষমতাসম্পন্ন ব্যক্তি বা যারা টিকা নেননি, তাদের সম্ভাব্য সংক্রমণের বিষয়ে দ্রুত চিকিৎসকের সঙ্গে যোগাযোগ করতে বলা হয়েছে।
উপসর্গ দেখা দিলে ঘরে থাকুন, স্কুল, কর্মক্ষেত্র বা বড় জমায়েত এড়িয়ে চলুন এবং দ্রুত চিকিৎসকের পরামর্শ নিন।
উল্লেখ্য, লস এঞ্জেলেস কাউন্টিতে সর্বশেষ হাম সংক্রমণের ঘটনা ঘটেছিল ২০২৫ সালের মার্চ মাসে। এ বছর ২৪ এপ্রিল পর্যন্ত যুক্তরাষ্ট্রে মোট ৮৮৪টি হাম আক্রান্তের ঘটনা রিপোর্ট করা হয়েছে, যার অধিকাংশই টেক্সাস, নিউ মেক্সিকো এবং ওকলাহোমার চলমান সংক্রমণের সঙ্গে সম্পর্কিত। আক্রান্তদের মধ্যে ১১ শতাংশকে হাসপাতালে ভর্তি করতে হয়েছে এবং তিনজনের মৃত্যু হয়েছে।
এলএবাংলাটাইমস/ওএম

 নিজস্ব প্রতিবেদক
নিজস্ব প্রতিবেদক

শেয়ার করুন